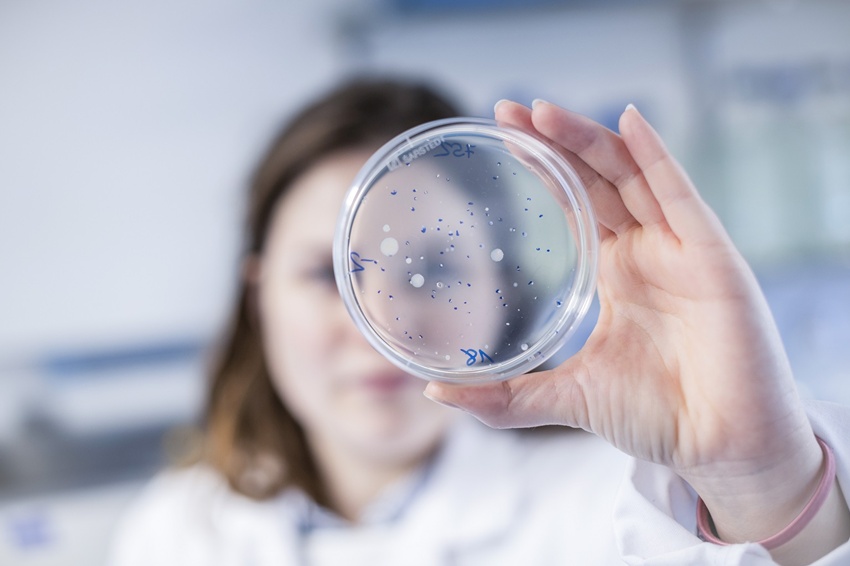

În cele peste trei decenii de activitate în România, Eisberg, cel mai important jucător pe piața salatelor gata de consum, și-a construit o excelentă reputație bazată, înainte de orice, pe calitatea și siguranța alimentului, mai mult chiar decât pe calitățile intrinseci ale salatelor.
„Fără niciun fel de compromis și de la bun început am aplicat, apărat și demonstrat standardele cele mai înalte de calitate și siguranță ale salatelor Eisberg spălate. Tocmai pentru că înțelegem în profunzime riscurile microbiologice și chimice la care sunt expuse aceste alimente pe cât de sănătoase, pe atât de fragile, exercităm un control total asupra produselor noastre. De la creșterea și recoltarea de la fermă la transportul, depozitarea, procesarea și livrarea salatelor noastre, adică de la fermă la client, știm în permanență și în detaliu ce intră și ce iese din Eisberg”, afirmă Gabriela Boldeanu, Quality Control manager la Eisberg România.
„Marii noștri clienți, conștienți, și ei, de aceleași riscuri, ne controlează și ne auditează inopinat, anual, și ne acordă înaltele lor certificări de calitate și siguranță alimentară”, completează Nicoleta Scarlat, Sales&Marketing manager al companiei.
Compania a investit permanent în modernizarea fabricii de la Cernica și a întregului lanț de aprovizionare, producție și distribuție, tocmai pentru a exercita acest control.
„Nu pot, așadar, decât să ne contrarieze ușor afirmații de presă potrivit cărora produsele noastre nu ar fi sigure pentru consum, din motive microbiologice sau din oricare altele”, explică Gabriela Boldeanu.
Ea amintește că toate produsele Eisberg România sunt supuse unui protocol încheiat între laboratoarele de analiză și autoritățile publice competente (ANSVSA și Direcțiile locale ale acesteia), prin care orice laborator ce descoperă rezultate neconforme la analiza produselor sesizează imediat atât producătorul, cât și Direcția Sanitar-Veterinară și de Siguranță Alimentară. Nu a existat o astfel de sesizare, ca urmare a analizei evocate recent în mass-media.
Încrederea clienților, fondată tocmai pe calitatea desăvârșită a produselor și lipsa incidentelor, oferă companiei certitudinea că produsele sale sunt mai presus de acuzații nefondate și lipsite de dovezi certe.
„Îi invităm pe toți cei care au dubii cu privire la calitatea și siguranța alimentară a salatelor Eisberg spălate și ambalate să le trimită la control instituțiilor publice abilitate sau să se programeze la o vizită și să vadă, cu ochii lor, câtă grijă avem de produsele noastre. Informați-vă înainte de a vă forma o opinie!”, conchide Nicoleta Scarlat.